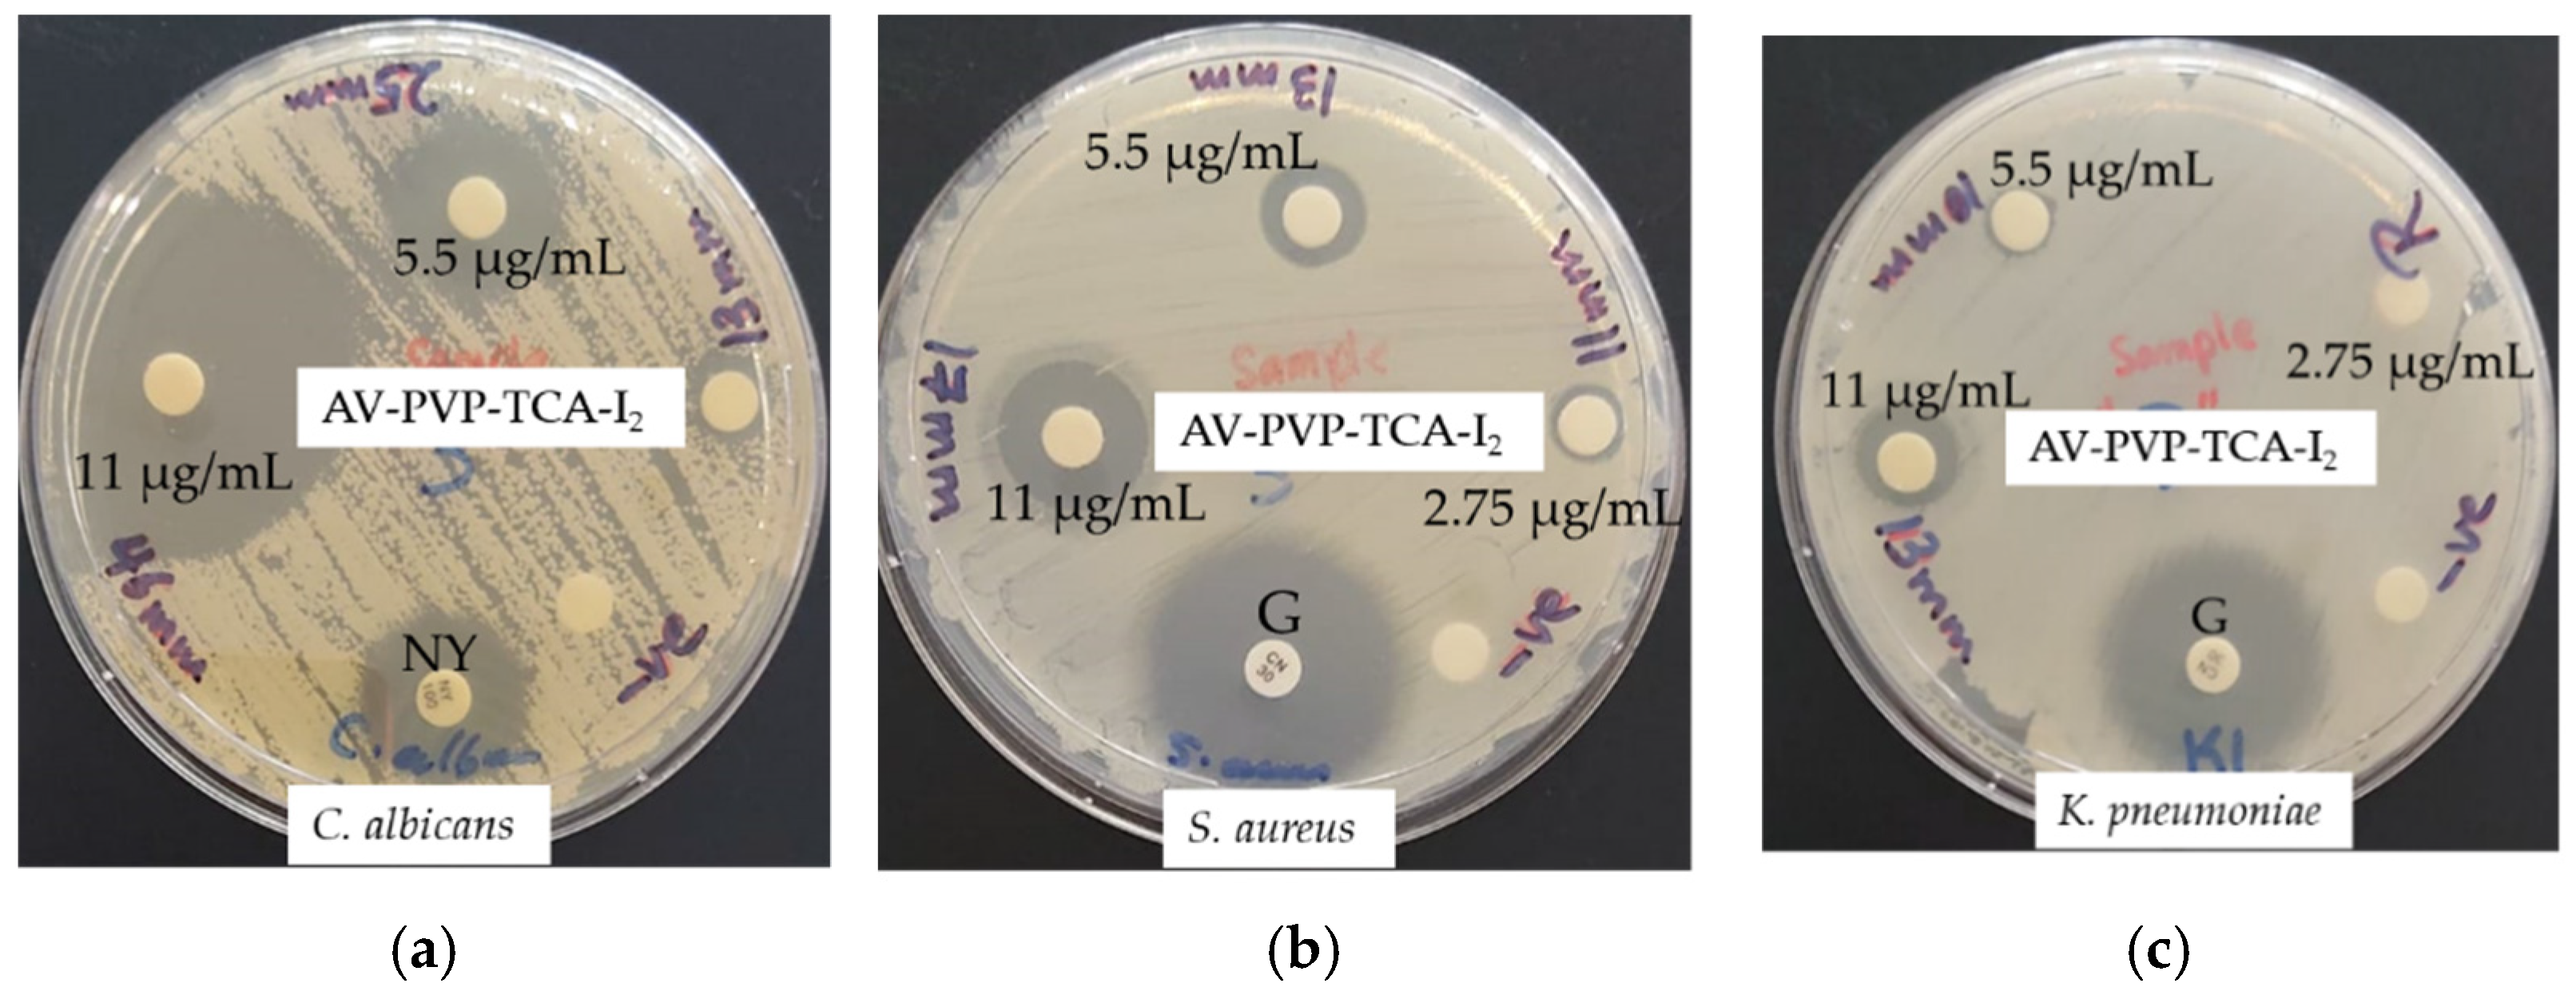
Polymers 14 01932 g009 550
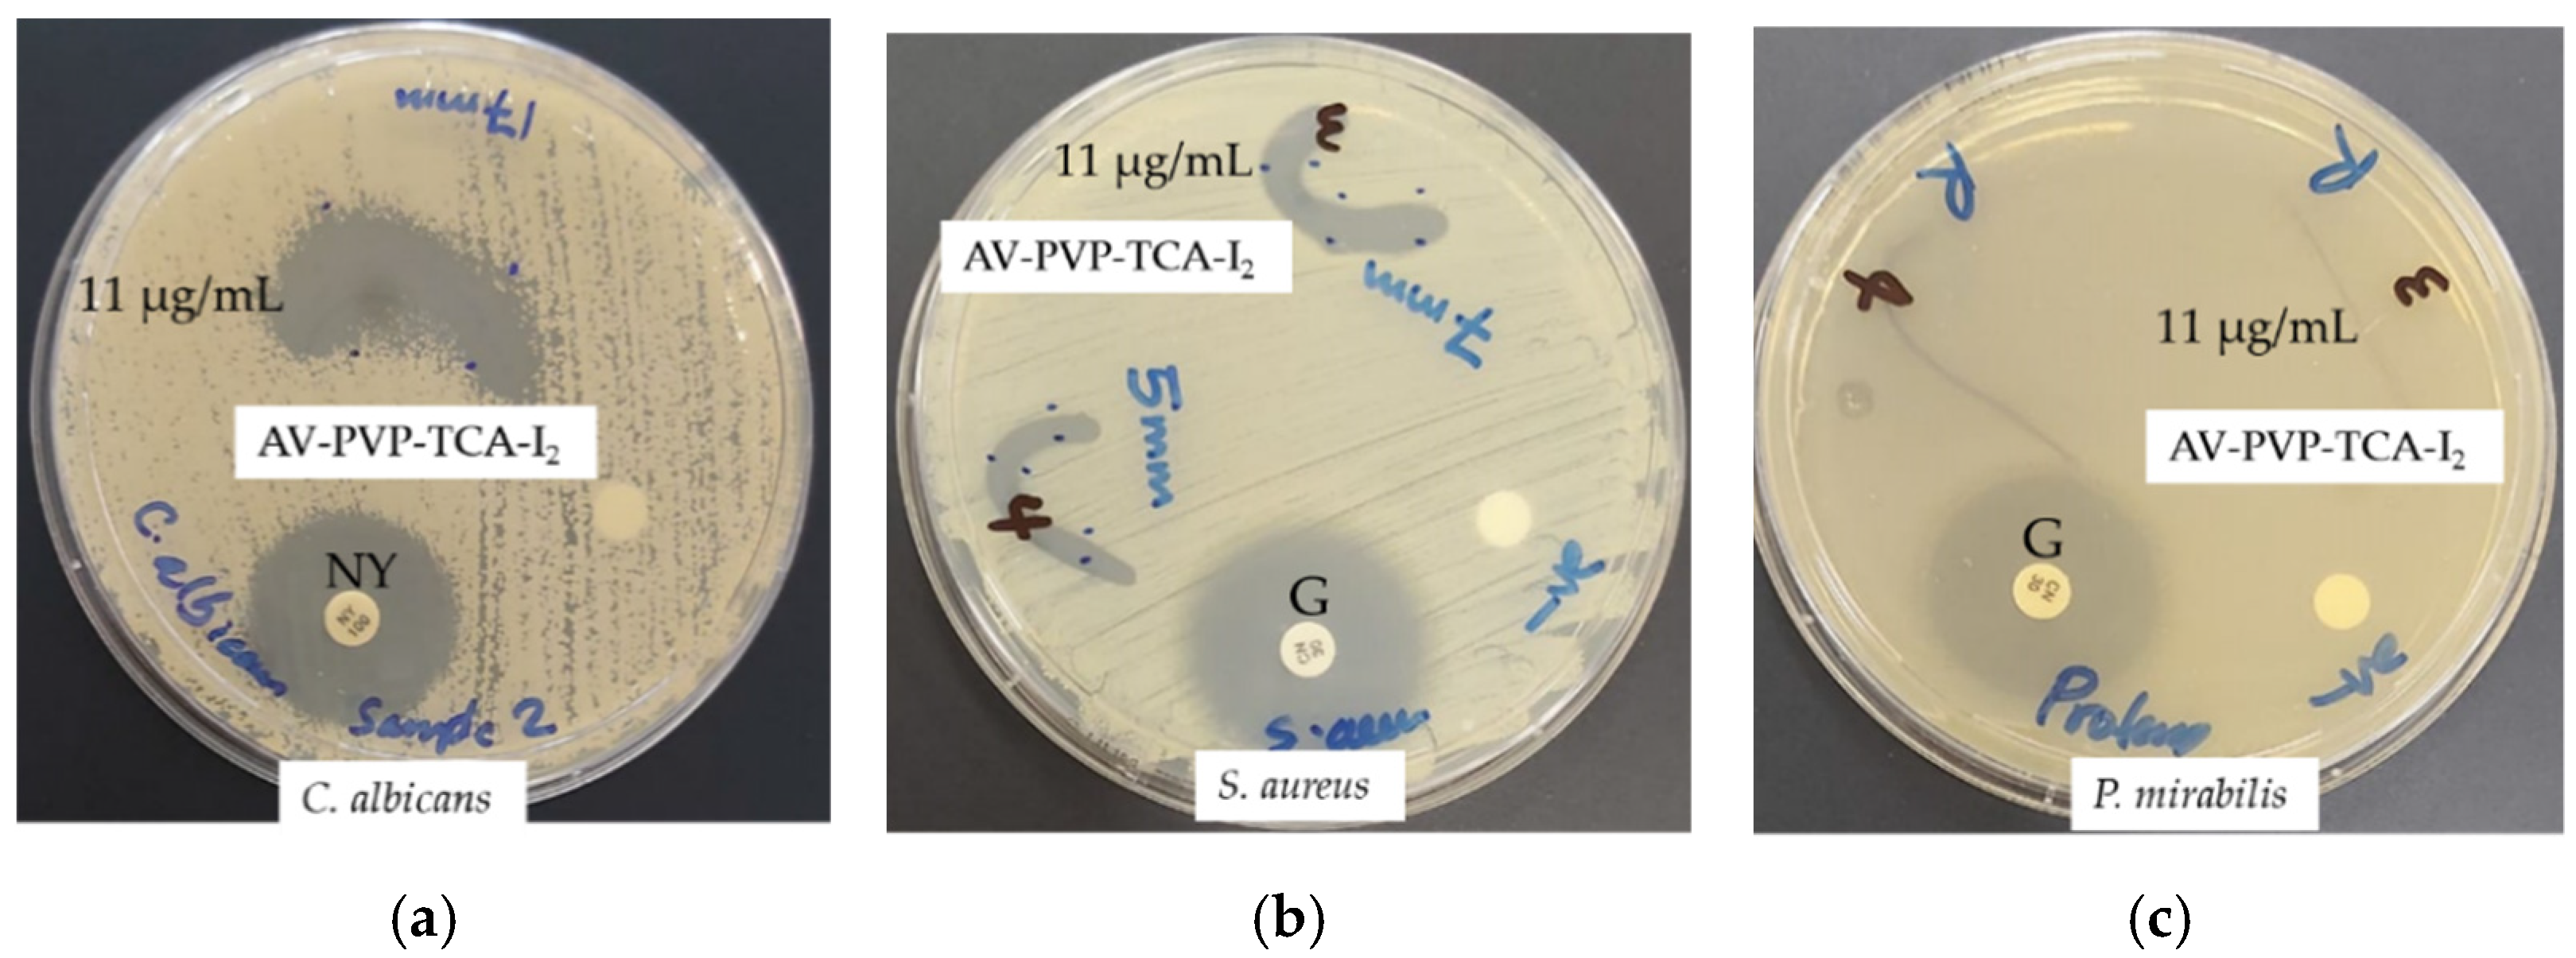
Polymers 14 01932 g010 550
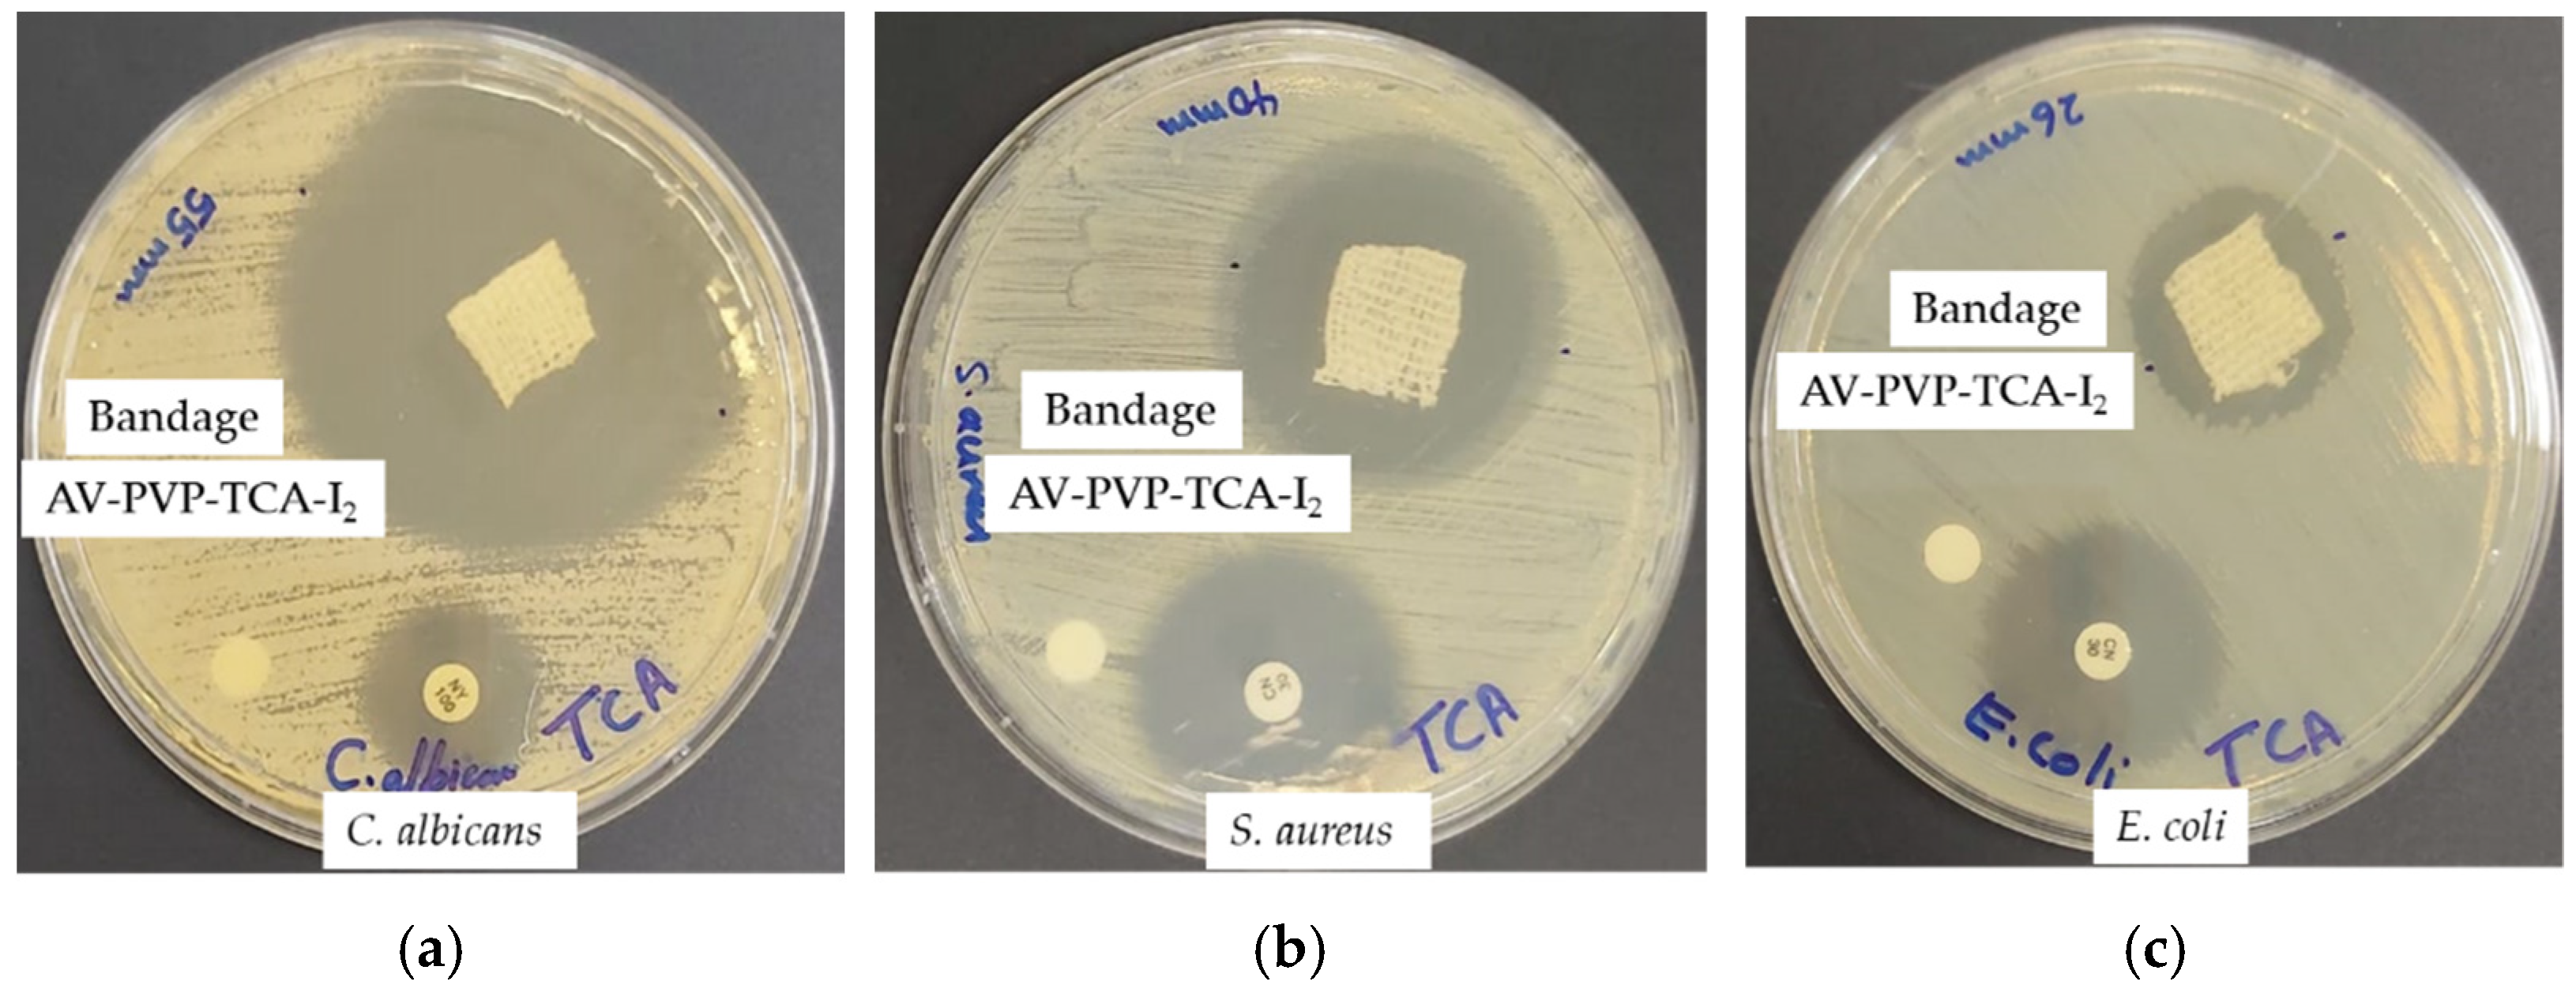
Polymers 14 01932 g012 550

Antimicrobial Biomaterial on Sutures, Bandages and Face Masks with Potential for Infection Control
Abstract
:1. Introduction
2. Materials and Methods
2.1. Materials
2.2. Preparation of Aloe vera (AV) Extract
2.3. Preparation of AV-PVP-TCA and AV-PVP-TCA-I2
2.4. Characterization of AV Complexes
2.4.1. Scanning Electron Microscopy (SEM) and Energy-Dispersive X-ray Spectroscopy (EDX)
2.4.2. UV-Vis Spectrophotometry (UV-Vis)
2.4.3. Raman Spectroscopy
2.4.4. Fourier Transform Infrared (FTIR) Spectroscopy
2.4.5. X-ray Diffraction (XRD)
2.5. Bacterial Strains and Culturing
2.6. Determination of Antimicrobial Properties of AV-PVP-TCA-I2
2.6.1. Procedure for Zone of Inhibition Plate Studies
2.6.2. Disc Diffusion Method
2.7. Preparation and Analysis of Impregnated Sutures, Bandages and Surgical Face Masks
2.8. Statistical Analysis
3. Results and Discussion
3.1. Elemental Composition and Morphological Examination of AV-PVP-TCA-I2
3.2. Spectroscopical Characterization
3.2.1. Raman Spectroscopy
3.2.2. UV-Vis Spectroscopy
3.2.3. Fourier Transform Infrared (FTIR) Spectroscopy
3.2.4. X-ray Diffraction (XRD)
3.3. Antimicrobial Activities of AV-PVP-TCA and AV-PVP-TCA-I2
4. Conclusions
Supplementary Materials
Author Contributions
Funding
Institutional Review Board Statement
Informed Consent Statement
Data Availability Statement
Acknowledgments
Conflicts of Interest
References
- Mahoney, A.R.; Safaee, M.M.; Wuest, W.M.; Furst, A.L. The silent pandemic: Emergent antibiotic resistances following the global response to SARS-CoV-2. iScience 2021, 24, 102304. [Google Scholar] [CrossRef] [PubMed]
- Ranney, M.L.; Griffeth, V.; Jha, A.K. Critical supply shortages—The need for ventilators and personal protective equipment during the COVID-19 pandemic. N. Engl. J. Med. 2020, 382, e41. [Google Scholar] [CrossRef] [PubMed]
- Bloukh, S.H.; Edis, Z.; Shaikh, A.A.; Pathan, H.M. A Look behind the Scenes at COVID-19: National Strategies of Infection Control and Their Impact on Mortality. Int. J. Environ. Res. Public Health 2020, 17, 5616. [Google Scholar] [CrossRef] [PubMed]
- Mulani, M.S.; Kamble, E.E.; Kumkar, S.N.; Tawre, M.S.; Pardesi, K.R. Emerging Strategies to Combat ESKAPE Pathogens in the Era of Antimicrobial Resistance: A Review. Front. Microbiol. 2019, 10, 539–563. [Google Scholar] [CrossRef] [PubMed]
- Chen, X.; Liao, B.; Cheng, L.; Peng, X.; Xu, X.; Li, Y.; Hu, T.; Li, J.; Zhou, X.; Ren, B. The microbial coinfection in COVID-19. Appl. Microbiol. Biotechnol. 2020, 104, 7777–7785. [Google Scholar] [CrossRef] [PubMed]
- Rawson, T.M.; Moore, L.S.P.; Zhu, N.; Ranganathan, N.; Skolimowska, K.; Gilchrist, M.; Satta, G.; Cooke, G.; Holmes, A. Bacterial and fungal co-infection in individuals with coronavirus: A rapid review to support COVID-19 antimicrobial prescribing. Clin. Infect. Dis. 2020, 71, 2459–2468. [Google Scholar] [CrossRef]
- Avire, N.J.; Whiley, H.; Ross, K. A Review of Streptococcus pyogenes: Public health risk factors, prevention and control. Pathogens 2021, 10, 248. [Google Scholar] [CrossRef]
- Mahalingam, S.S.; Jayaraman, S.; Pandiyan, P. Fungal Colonization and Infections—Interactions with Other Human Diseases. Pathogens 2022, 11, 212. [Google Scholar] [CrossRef]
- Cassini, A.; Hogberg, L.D.; Plachouras, D.; Quattrocchi, A.; Hoxha, A.; Simonsen, G.S.; Colomb-Cotinat, M.; Kretzschmar, M.E.; Devleesschauwer, B.; Cecchini, M.; et al. Attributable deaths and disability-adjusted life-years caused by infections with antibiotic-resistant bacteria in the EU and the European Economic Area in 2015: A population-level modelling analysis. Lancet Infect. Dis. 2019, 19, 56–66. [Google Scholar] [CrossRef] [Green Version]
- Kampf, G.; Todt, D.; Pfaender, S.; Steinmann, E. Persistence of coronaviruses on inanimate surfaces and their inactivation with biocidal agents. J. Hosp. Infect. 2020, 104, 246–251. [Google Scholar] [CrossRef] [Green Version]
- Rao, H.; Choo, S.; Rajeswari Mahalingam, S.R.; Adisuri, D.S.; Madhavan, P.; Md. Akim, A.M.; Chong, P.P. Approaches for Mitigating Microbial Biofilm-Related Drug Resistance: A Focus on Micro- and Nanotechnologies. Molecules 2021, 26, 1870. [Google Scholar] [CrossRef] [PubMed]
- Kaiho, T. Iodine Chemistry and Applications, 1st ed.; Kaiho, T., Ed.; John Wiley & Sons, Inc.: Hoboken, NJ, USA, 2015; pp. 15–410. ISBN 78-1-118-46629-2. [Google Scholar]
- Zhang, Q.; Wu, Z.; Liu, F.; Liu, S.; Liu, J.; Wang, Y.; Yan, T. Encapsulating a high content of iodine into an active graphene substrate as a cathode material for high-rate lithium–iodine batteries. J. Mater. Chem. A 2017, 5, 15235–15242. [Google Scholar] [CrossRef]
- Yao, L.; Xu, P.; Gao, W.; Li, J.; Gao, L.; Niu, G.; Li, D.; Chen, S.; Tang, J. A chain-type diamine strategy towards strongly anisotropic triiodide of DMEDA·I6. Sci. China Mat. 2020, 63, 566–574. [Google Scholar] [CrossRef] [Green Version]
- Ordinartsev, A.A.; Petrov, A.A.; Lyssenko, K.A.; Petrov, A.V.; Goodilin, E.A.; Tarasov, A.B. Crystal structure of new formamidinium triiodide jointly refined by single-crystal XRD, Raman scattering spectroscopy and DFT assessment of hydrogen-bond network features. Acta Cryst. 2021, E77, 692–695. [Google Scholar] [CrossRef] [PubMed]
- Moulay, S. Molecular iodine/polymer complexes. J. Polym. Eng. 2013, 33, 389–443. [Google Scholar] [CrossRef]
- Moulay, S. Macromolecule/Polymer-Iodine Complexes: An Update. Recent Innov. Chem. Eng. 2019, 12, 174. [Google Scholar] [CrossRef]
- Vasudevan, P.; Tandon, M. Antimicrobial properties of iodine based products. J. Sci. Ind. Res. 2010, 69, 376–383. [Google Scholar]
- Gillam, T.A.; Goh, C.K.; Ninan, N.; Bilimoria, K.; Shirazi, H.S.; Saboohi, S.; Al-Bataineh, S.; Whittle, J.; Blencowe, A. Iodine complexed poly(vinylpyrrolidone) plasma polymers as broad spectrum antiseptic coating. Appl. Surf. Sci. 2021, 537, 147866. [Google Scholar] [CrossRef]
- Bigliardi, P.L.; Alsagoff, S.A.L.; El-Kafrawi, H.Y.; Pyon, J.-K.; Wa, C.T.C.; Villa, M.A. Povidone iodine in wound healing: A review of current concepts and practices. Int. J. Surg. 2017, 44, 260–268. [Google Scholar] [CrossRef]
- Gao, T.; Fan, H.; Wang, X.; Gao, Y.; Liu, W.; Chen, W.; Dong, A.; Wang, Y.J. Povidone-Iodine-Based Polymeric Nanoparticles for Antibacterial applications. ACS Appl. Mater. Interfaces 2017, 9, 25738–25746. [Google Scholar] [CrossRef]
- Ma, J.; Zhang, Y.; Zhang, D.; Niu, X.; Lin, Z. Insights into the molecular interaction between poly(vinylpyrrolidone)-iodine disinfection system and polypropylene microplastics in aquatic environment. Chem. Eng. J. 2022, 430, 132276. [Google Scholar] [CrossRef]
- Xu, X.; Guan, Y. Investigating the Complexation and Release Behaviors of Iodine in Poly(vinylpyrrolidone)-Iodine Systems through Experimental and Computational Approaches. Ind. Eng. Chem. Res. 2020, 59, 22667–22676. [Google Scholar] [CrossRef]
- Viswanathan, K.; Babu, D.B.; Jayakumar, G.; Raj, G.D. Anti-microbial and skin wound dressing application of molecular iodine nanoparticles. Mater. Res. Express 2017, 4, 104003. [Google Scholar] [CrossRef]
- Edis, Z.; Raheja, R.; Bloukh, S.H.; Bhandare, R.R.; Sara, H.A.; Reiss, G.J. Antimicrobial Hexaaquacopper(II) Complexes with Novel Polyiodide Chains. Polymers 2021, 13, 1005. [Google Scholar] [CrossRef] [PubMed]
- Bloukh, S.H.; Edis, Z. Structure and Antimicrobial properties of bis(1,4,7,10-tetraoxacyclododecane-κ4O,O′,O′′,O′′′)cesium pentaiodide, C16H32CsI5O8. Z. Krist. NCS 2020, 235, 759–761. [Google Scholar] [CrossRef] [Green Version]
- Wang, M.; Takahama, T.; Tashiro, K. Crystalline Iodine Complexes of Amorphous Poly(vinyl acetate) as Studied by X-ray Diffraction, Vibrational Spectroscopy, and Computer Simulation. Macromolecules 2020, 53, 4395–4406. [Google Scholar] [CrossRef]
- Tashiro, K.; Takahama, T.; Wang, M.F. X-ray study of Poly(vinyl Alcohol)-Iodine complex prepared from the dilute iodine solution as a hint to know the inner structure of polarizer. Polymer 2021, 233, 124180. [Google Scholar] [CrossRef]
- Blake, A.J.; Li, W.S.; Lippolis, V.; Schröder, M.; Devillanova, F.A.; Gould, R.O.; Parsons, S.; Radek, C. Template self-assembly of polyiodide networks. Chem. Soc. Rev. 1998, 27, 195–206. [Google Scholar] [CrossRef]
- Savastano, M.; Bazzicalupi, C.; Gellini, C.; Bianchi, A. Genesis of Complex Polyiodide Networks: Insights on the Blue Box/I−/I2 Ternary System. Crystals 2020, 10, 387. [Google Scholar] [CrossRef]
- Edis, Z.; Bloukh, S.H. Preparation and structural and spectroscopic characterization of a pentaiodide [Rb(12-crown-4)2]I5. Z. Nat. 2013, 68, 1340–1346. [Google Scholar]
- Okuda, M.; Hiramatsu, T.; Yasuda, M.; Ishigaki, M.; Ozaki, Y.; Hayashi, M.; Tominaga, K.; Chatani, E. Theoretical Modeling of Electronic Structures of Polyiodide Species Included in α-Cyclodextrin. J. Phys. Chem. B 2020, 124, 4089–4096. [Google Scholar] [CrossRef] [PubMed]
- Haj Bloukh, S.; Edis, Z. Halogen bonding in Crystal structure of bis(1,4,7,10-tetraoxacyclododecane-κ4O,O′,O′′,O′′′)cesium triiodide, C16H32CsI3O8. Z. Krist. New Cryst. Struct. 2020, 235, 717–719. [Google Scholar] [CrossRef] [Green Version]
- Edis, Z.; Bloukh, S.H. Preparation and structural and spectroscopic characterization of triiodides [M(12-crown-4)2]I3 with M = Na and Rb. Z. Nat. 2014, 69, 995–1002. [Google Scholar]
- Van Mengen, M.; Reiss, G.J. I62− Anion composed of two asymmetric triiodide moieties: A competition between halogen and hydrogen bond. Inorganics 2013, 1, 3–13. [Google Scholar] [CrossRef]
- Edis, Z.; Haj Bloukh, S.; Abu Sara, H.; Bhakhoa, H.; Rhyman, L.; Ramasami, P. “Smart” triiodide compounds: Does halogen bonding influence antimicrobial activities? Pathogens 2019, 8, 182. [Google Scholar] [CrossRef] [Green Version]
- Schmitz, G.; Rosenblatt, L.; Salerno, N.; Odette, J.; Ren, R.; Emanuel, T.; Michalek, J.; Liu, Q.; Du, L.; Jahangir, K.; et al. Treatment data using a topical povidone-iodine antiseptic in patients with superficial skin abscesses. Data Brief 2019, 23, 103715. [Google Scholar] [CrossRef]
- Haj Bloukh, S.; Edis, Z.; Abu Sara, H.; Alhamaidah, M.A. Antimicrobial Properties of Lepidium sativum L. Facilitated Silver Nanoparticles. Pharmaceutics 2021, 13, 1352. [Google Scholar] [CrossRef]
- Bloukh, S.H.; Edis, Z.; Ibrahim, M.R.; Abu Sara, H. “Smart” antimicrobial nanocomplexes with potential to decrease surgical site infections (SSI). Pharmaceutics 2020, 12, 361. [Google Scholar] [CrossRef] [Green Version]
- Reda, M.; Ashames, A.; Edis, Z.; Bloukh, S.; Bhandare, R.; Abu Sara, H. Green Synthesis of Potent Antimicrobial Silver Nanoparticles Using Different Plant Extracts and Their Mixtures. Processes 2019, 7, 510. [Google Scholar] [CrossRef] [Green Version]
- Edis, Z.; Bloukh, S.H. Facile Synthesis of Antimicrobial Aloe Vera-“Smart” Triiodide-PVP Biomaterials. Biomimetics 2020, 5, 45. [Google Scholar] [CrossRef]
- Edis, Z.; Bloukh, S.H. Facile Synthesis of Bio-Antimicrobials with “Smart” Triiodides. Molecules 2021, 26, 3553. [Google Scholar] [CrossRef] [PubMed]
- Joseph, B.; George, A.; Gopi, S.; Kalarikkal, N.; Thomas, S. Polymer sutures for simultaneous wound healing and drug delivery—A review. Int. J. Pharm. 2017, 524, 454–466. [Google Scholar] [CrossRef] [PubMed]
- Bhatia, P.; Sharma, A.; George, A.J.; Anvitha, D.; Kumar, P.; Dwivedi, V.P.; Chandra, N.S. Antibacterial activity of medicinal plants against ESKAPE: An update. Heliyon 2021, 7, e06310. [Google Scholar] [CrossRef] [PubMed]
- Zhao, Q.; Luan, X.; Zheng, M.; Tian, X.-H.; Zhao, J.; Zhang, W.-D.; Ma, B.-L. Synergistic Mechanisms of Constituents in Herbal Extracts during Intestinal Absorption: Focus on Natural Occurring Nanoparticles. Pharmaceutics 2020, 12, 128. [Google Scholar] [CrossRef] [Green Version]
- Godlewska-Żyłkiewicz, B.; Świsłocka, R.; Kalinowska, M.; Golonko, A.; Świderski, G.; Arciszewska, Ż.; Nalewajko-Sieliwoniuk, E.; Naumowicz, M.; Lewandowski, W. Biologically Active Compounds of Plants: Structure-Related Antioxidant, Microbiological and Cytotoxic Activity of Selected Carboxylic Acids. Materials 2020, 13, 4454. [Google Scholar] [CrossRef]
- Malheiro, J.F.; Maillard, J.-Y.; Borges, F.; Simões, M. Biocide Potentiation Using Cinnamic Phytochemicals and Derivatives. Molecules 2019, 24, 3918. [Google Scholar] [CrossRef] [Green Version]
- Souto, E.B.; Ribeiro, A.F.; Ferreira, M.I.; Teixeira, M.C.; Shimojo, A.A.M.; Soriano, J.L.; Naveros, B.C.; Durazzo, A.; Lucarini, M.; Souto, S.B.; et al. New Nanotechnologies for the Treatment and Repair of Skin Burns Infections. Int. J. Mol. Sci. 2020, 21, 393. [Google Scholar] [CrossRef] [Green Version]
- Bianchera, A.; Catanzano, O.; Boateng, J.; Elviri, L. The place of biomaterials in wound healing. In Therapeutic Dressings and Wound Healing Applications; John Wiley & Sons: Hoboken, NJ, USA, 2020; pp. 337–366. [Google Scholar]
- Rezvani Ghomi, E.; Khalili, S.; Nouri Khorasani, S.; Esmaeely Neisiany, R.; Ramakrishna, S. Wound dressings: Current advances and future directions. J. Appl. Polym. Sci. 2019, 136, 47738. [Google Scholar] [CrossRef] [Green Version]
- Reczyńska-Kolman, K.; Hartman, K.; Kwiecień, K.; Brzychczy-Włoch, M.; Pamuła, E. Composites Based on Gellan Gum, Alginate and Nisin-Enriched Lipid Nanoparticles for the Treatment of Infected Wounds. Int. J. Mol. Sci. 2022, 23, 321. [Google Scholar] [CrossRef]
- Schulte-Werning, L.V.; Murugaiah, A.; Singh, B.; Johannessen, M.; Engstad, R.E.; Škalko-Basnet, N.; Holsæter, A.M. Multifunctional Nanofibrous Dressing with Antimicrobial and Anti-Inflammatory Properties Prepared by Needle-Free Electrospinning. Pharmaceutics 2021, 13, 1527. [Google Scholar] [CrossRef]
- Tummalapalli, M.; Berthet, M.; Verrier, B.; Deopura, B.L.; Alam, M.S.; Gupta, B. Composite wound dressings of pectin and gelatin with Aloe vera and curcumin as bioactive agents. Int. J. Biol. Macromol. 2016, 82, 104–113. [Google Scholar] [CrossRef] [PubMed]
- Goudarzi, M.; Fazeli, M.; Azad, M.; Seyedjavadi, S.S.; Mousavi, R. Aloe vera gel: Effective Therapeutic Agent against Multidrug-Resistant Pseudomonas aeruginosa Isolates Recovered from Burn Wound Infections. Chemother. Res. Pract. 2015, 2015, 639806. [Google Scholar] [CrossRef] [PubMed] [Green Version]
- Ahmed, J.; Altun, E.; Aydogdu, M.O.; Gunduz, O.; Kerai, L.; Ren, G.; Edirisinghe, M. Anti-fungal bandages containing cinnamon extract. Int. Wound J. 2019, 16, 730–736. [Google Scholar] [CrossRef] [PubMed] [Green Version]
- Ahmed, J.; Gultekinoglu, M.; Bayram, C.; Kart, D.; Ulubayram, K.; Edirisinghe, M. Alleviating the toxicity concerns of antibacterial cinnamon-polycaprolactone biomaterials for healthcare-related biomedical applications. MedComm 2021, 2, 236–246. [Google Scholar] [CrossRef]
- Wang, S.; Kang, O.-H.; Kwon, D.-Y. Trans-Cinnamaldehyde Exhibits Synergy with Conventional Antibiotic against Methicillin-Resistant Staphylococcus aureus. Int. J. Mol. Sci. 2021, 22, 2752. [Google Scholar] [CrossRef]
- Saleh, N.; Bufaroosha, M.S.; Moussa, Z.; Bojesomo, R.; Al-Amodi, H.; Al-Ahdal, A. Encapsulation of Cinnamic Acid by Cucurbit [7]uril for Enhancing Photoisomerization. Molecules 2020, 25, 3702. [Google Scholar] [CrossRef]
- Hanai, K.; Kuwae, A.; Takai, T.; Senda, H.; Kunimoto, K.-K. A comparative vibrational and NMR study of cis-cinnamic acid polymorphs and trans-cinnamic acid. Spectrochim. Acta A 2001, 57, 513–519. [Google Scholar] [CrossRef]
- Huang, X.; Wang, P.; Li, T.; Tian, X.; Guo, W.; Xu, B.; Huang, G.; Cai, D.; Zhou, F.; Zhang, H.; et al. Self-Assemblies Based on Traditional Medicine Berberine and Cinnamic Acid for Adhesion-Induced Inhibition Multidrug-Resistant Staphylococcus aureus. ACS Appl. Mater. Interfaces 2020, 12, 227–237. [Google Scholar] [CrossRef]
- Sánchez, M.; González-Burgos, E.; Iglesias, I.; Gómez-Serranillos, M.P. Pharmacological Update Properties of Aloe Vera and its Major Active Constituents. Molecules 2020, 25, 1324. [Google Scholar] [CrossRef] [Green Version]
- Liu, C.; Cui, Y.; Pi, F.; Cheng, Y.; Guo, Y.; Qian, H. Extraction, Purification, Structural Characteristics, Biological Activities and Pharmacological Applications of Acemannan, a Polysaccharide from Aloe vera: A Review. Molecules 2019, 24, 1554. [Google Scholar] [CrossRef] [Green Version]
- Donkor, A.; Donkor, M.N.; Kuubabongnaa, N. Evaluation of anti-infective potencies of formulated aloin A ointment and aloin A isolated from Aloe barbadensis Miller. BMC Chem. 2020, 14, 8. [Google Scholar] [CrossRef] [PubMed]
- Kuntić, V.; Pejic, N.; Mićić, S. Direct Spectrophotometric Determination of Hesperidin in Pharmaceutical Preparations. Acta Chim. Slov. 2012, 59, 436–441. [Google Scholar] [PubMed]
- Xiang, H.; Cao, F.; Ming, D.; Zheng, Y.; Dong, X.; Zhong, X.; Mu, D.; Li, B.; Zhong, L.; Cao, J.; et al. Aloe-emodin inhibits Staphylococcus aureus biofilms and extracellular protein production at the initial adhesion stage of biofilm development. Appl. Microbiol. Biotechnol. 2017, 101, 6671–6681. [Google Scholar] [CrossRef] [PubMed]
- Meza-Valle, K.Z.; Saucedo-Acuña, R.A.; Tovar-Carrillo, K.L.; Cuevas-González, J.C.; Zaragoza-Contreras, E.A.; Melgoza-Lozano, J. Characterization and Topical Study of Aloe Vera Hydrogel on Wound-Healing Process. Polymers 2021, 13, 3958. [Google Scholar] [CrossRef]
- Sun, Z.; Yu, C.; Wang, W.; Yu, G.; Zhang, T.; Zhang, L.; Zhang, J.; Wei, K. Aloe Polysaccharides Inhibit Influenza A Virus Infection—A Promising Natural Anti-flu Drug. Front. Microbiol. 2018, 9, 2338. [Google Scholar] [CrossRef] [PubMed]
- Borges-Argáez, R.; Chan-Balan, R.; Cetina-Montejo, L.; Ayora-Talavera, G.; Sansores-Peraza, P.; Gómez-Carballo, J.; Mirbella Cáceres-Farfán, M. In vitro evaluation of anthraquinones from Aloe vera (Aloe barbadensis Miller) roots and several derivatives against strains of influenza virus. Ind. Crop. Prod. 2019, 132, 468–475. [Google Scholar] [CrossRef]
- Paraiso, I.L.; Revel, J.S.; Stevens, J.F. Potential use of polyphenols in the battle against COVID-19. Curr. Opin. Food Sci. 2020, 32, 149–155. [Google Scholar] [CrossRef]
- Piccolella, S.; Crescente, G.; Faramarzi, S.; Formato, M.; Pecoraro, M.T.; Pacifico, S. Polyphenols vs. Coronaviruses: How Far Has Research Moved Forward? Molecules 2020, 25, 4103. [Google Scholar] [CrossRef]
- Mani, J.S.; Johnson, J.B.; Steel, J.C.; Broszczak, D.A.; Neilsen, P.M.; Walsh, K.B.; Naiker, M. Natural product-derived phytochemicals as potential agents against coronaviruses: A review. Virus Res. 2020, 284, 197989. [Google Scholar] [CrossRef]
- Tuñón-Molina, A.; Takayama, K.; Redwan, E.M.; Uversky, V.N.; Andrés, J.; Serrano-Aroca, Á. Protective Face Masks: Current Status and Future Trends. ACS Appl. Mat. Interfaces 2021, 13, 56725–56751. [Google Scholar] [CrossRef]
- Ray, S.S.; Lee, H.K.; Huyen, D.T.T.; Chen, S.-S.; Young-Nam Kwon, Y.-N. Microplastics waste in environment: A perspective on recycling issues from PPE kits and face masks during the COVID-19 pandemic. Environ. Technol. Innov. 2022, 26, 102290. [Google Scholar] [CrossRef] [PubMed]
- Jung, S.; Yang, J.-Y.; Byeon, E.-Y.; Kim, D.-G.; Lee, D.-G.; Ryoo, S.; Lee, S.; Shin, C.-W.; Jang, H.W.; Kim, H.J.; et al. Copper-Coated Polypropylene Filter Face Mask with SARS-CoV-2 Antiviral Ability. Polymers 2021, 13, 1367. [Google Scholar] [CrossRef] [PubMed]
- Chowdhury, M.A.; Shuvho, M.B.A.; Shahid, M.A.; Haque, A.K.M.M.; Kashem, M.A.; Lam, S.S.; Ong, H.C.; Uddin, M.A.; Mofijur, M. Prospect of Biobased Antiviral Face Mask to Limit the Coronavirus Outbreak. Environ. Res. 2021, 192, 110294. [Google Scholar] [CrossRef] [PubMed]
- Lu, W.-C.; Chen, C.-Y.; Cho, C.-J.; Venkatesan, M.; Chiang, W.-H.; Yu, Y.-Y.; Lee, C.-H.; Lee, R.-H.; Rwei, S.-P.; Kuo, C.-C. Antibacterial Activity and Protection Efficiency of Polyvinyl Butyral Nanofibrous Membrane Containing Thymol Prepared through Vertical Electrospinning. Polymers 2021, 13, 1122. [Google Scholar] [CrossRef] [PubMed]
- Takayama, K.; Tuñón-Molina, A.; Cano-Vicent, A.; Muramoto, Y.; Noda, T.; Aparicio-Collado, J.L.; Sabater i Serra, R.; Martí, M.; Serrano-Aroca, Á. Non-Woven Infection Prevention Fabrics Coated with Biobased Cranberry Extracts Inactivate Enveloped Viruses Such as SARS-CoV-2 and Multidrug-Resistant Bacteria. Int. J. Mol. Sci. 2021, 22, 12719. [Google Scholar] [CrossRef] [PubMed]
- Borojeni, I.A.; Gajewski, G.; Riahi, R.A. Application of Electrospun Nonwoven Fibers in Air Filters. Fibers 2022, 10, 15. [Google Scholar] [CrossRef]
- Rahman, M.Z.; Hoque, M.E.; Alam, M.R.; Rouf, M.A.; Khan, S.I.; Xu, H.; Ramakrishna, S. Face Masks to Combat Coronavirus (COVID-19)—Processing, Roles, Requirements, Efficacy, Risk and Sustainability. Polymers 2022, 14, 1296. [Google Scholar] [CrossRef]
- Fonseca, A.C.; Lima, M.S.; Sousa, A.F.; Silvestre, A.J.; Coelho, J.F.J.; Serra, A.C. Cinnamic acid derivatives as promising building blocks for advanced polymers: Synthesis, properties and applications. Polym. Chem. 2019, 10, 1696–1723. [Google Scholar] [CrossRef]
- Panda, P.K.; Yang, J.-M.; Chang, Y.-H. Preparation and characterization of ferulic acid-modified water soluble chitosan and poly (γ-glutamic acid) polyelectrolyte films through layer-by-layer assembly towards protein adsorption. Int. J. Biol. Macromol. 2021, 171, 457–464. [Google Scholar] [CrossRef]
- Alfuraydi, R.T.; Alminderej, F.M.; Mohamed, N.A. Evaluation of Antimicrobial and Anti-Biofilm Formation Activities of Novel Poly (vinyl alcohol) Hydrogels Reinforced with Crosslinked Chitosan and Silver Nano-Particles. Polymers 2022, 14, 1619. [Google Scholar] [CrossRef]
- Chandel, A.K.S.; Shimizu, A.; Hasegawa, K.; Ito, T. Advancement of Biomaterial-Based Postoperative Adhesion Barriers. Macromol. Biosci. 2021, 21, 2000395. [Google Scholar] [CrossRef] [PubMed]
- Chandel, A.K.S.; Kumar, C.U.; Jewrajka, S.K. Release Performance of Biodegradable/Cytocompatible Agarose–Polyethylene Glycol–Polycaprolactone Amphiphilic Co-Network Gels. ACS Appl. Mater. Interfaces 2016, 8, 3182–3192. [Google Scholar] [CrossRef] [PubMed]
- Bera, A.; Chandel, A.K.S.; Kumar, C.U.; Jewrajka, S.K. Degradable/cytocompatible and pH responsive amphiphilic conetwork gels based on agarose-graft copolymers and polycaprolactone. J. Mater. Chem. B 2015, 3, 8548–8557. [Google Scholar] [CrossRef] [PubMed]
- Ohta, S.; Mitsuhashi, K.; Chandel, A.K.S.; Qi, P.; Nakamura, N.; Nakamichi, A.; Yoshida, H.; Yamaguchi, G.; Hara, Y.; Sasaki, R.; et al. Silver-loaded carboxymethyl cellulose nonwoven sheet with controlled counterions for infected wound healing. Carbohydr. Polym. 2022, 286, 119289. [Google Scholar] [CrossRef] [PubMed]
- Chandel, A.K.S.; Nutan, B.; Raval, I.H.; Suresh, K.; Jewrajka, S.K. Self-Assembly of Partially Alkylated Dextran-graft-poly[(2-dimethylamino)ethyl methacrylate] Copolymer Facilitating Hydrophobic/Hydrophilic Drug Delivery and Improving Conetwork Hydrogel Properties. Biomacromolecules 2018, 19, 1142–1153. [Google Scholar] [CrossRef] [PubMed]
- Prundeanu, M.; Brezoiu, A.-M.; Deaconu, M.; Gradisteanu Pircalabioru, G.; Lincu, D.; Matei, C.; Berger, D. Mesoporous Silica and Titania-Based Materials for Stability Enhancement of Polyphenols. Materials 2021, 14, 6457. [Google Scholar] [CrossRef] [PubMed]
- Freeman, C.; Duan, E.; Kessler, J. Molecular iodine is not responsible for cytotoxicity in iodophors. J. Hosp. Inf. 2022, in press. [Google Scholar] [CrossRef]
- Savastano, M.; Bazzicalupi, C.; García, C.; Gellini, C.; López de la Torre, M.D.; Mariani, P.; Pichierri, F.; Bianchi, A.; Melguizo, M. Iodide and triiodide anion complexes involving anion–π interactions with a tetrazine-based receptor. Dalton Trans. 2017, 46, 4518. [Google Scholar] [CrossRef]
- Lundin, J.G.; McGann, C.L.; Weise, N.K.; Estrella, L.A.; Balow, R.B.; Streifel, B.C.; Wynne, J.H. Iodine binding and release from antimicrobial hemostatic polymer foams. React. Funct. Polym. 2019, 135, 44–51. [Google Scholar] [CrossRef]
- Shestimerova, T.A.; Mironov, A.V.; Bykov, M.A.; Grigorieva, A.V.; Wei, Z.; Dikarev, E.V.; Shevelkov, A.V. Assembling Polyiodides and Iodobismuthates Using a Template Effect of a Cyclic Diammonium Cation and Formation of a Low-Gap Hybrid Iodobismuthate with High Thermal Stability. Molecules 2020, 25, 2765. [Google Scholar] [CrossRef]
- Bauer, A.W.; Perry, D.M.; Kirby, W.M.M. Single-disk antibiotic-sensitivity testing of staphylococci: An analysis of technique and results. AMA Arch. Intern. Med. 1959, 104, 208–216. [Google Scholar] [CrossRef]
- Clinical and Laboratory Standards Institute (CLSI). Performance Standards for Antimicrobial Disk Susceptibility Testing, 28th ed.; M100S; CLSI: Wayne, PA, USA, 2018; Volume 38. [Google Scholar]
- Sai, M.; Zhong, S.; Tang, Y.; Ma, W.; Sun, Y.; Ding, D. Research on the preparation and antibacterial properties of 2-N-thiosemicarbazide-6-O-hydroxypropyl chitosan membranes with iodine. J. Appl. Polym. Sci. 2014, 131, 1–8. [Google Scholar] [CrossRef]
- Laus, M.; Li, W.; Zhao, X.; Sun, X.; Zu, Y.; Liu, Y.; Ge, Y. Evaluation of Antioxidant Ability In Vitro and Bioavailability of trans-Cinnamic Acid Nanoparticle by Liquid Antisolvent Precipitate. J. Nanomater. 2016, 2016, 9518362. [Google Scholar] [CrossRef] [Green Version]
- Mamatha, G.; Rajulu, A.V.; Madhukar, K. In Situ Generation of Bimetallic Nanoparticles in Cotton Fabric Using Aloe Vera Leaf Extract, as a Reducing Agent. J. Nat. Fibers 2020, 17, 1121–1129. [Google Scholar] [CrossRef]
- Aziz, S.B.; Abdullah, O.G.; Hussein, S.A.; Ahmed, H.M. Effect of PVA Blending on Structural and Ion Transport Properties of CS: AgNt-Based Polymer Electrolyte Membrane. Polymers 2017, 9, 622. [Google Scholar] [CrossRef] [PubMed] [Green Version]
- Aghamohamadi, N.; Sanjani, N.S.; Majidi, R.F.; Nasrollahi, S.A. Preparation and characterization of Aloe vera acetate and electrospinning fibers as promising antibacterial properties materials. Mater. Sci. Eng. C 2019, 94, 445–452. [Google Scholar] [CrossRef] [PubMed]
- Yushina, I.; Tarasova, N.; Kim, D.; Sharutin, V.; Bartashevich, E. Noncovalent Bonds, Spectral and Thermal Properties of Substituted Thiazolo [2,3-b][1,3]thiazinium Triiodides. Crystals 2019, 9, 506. [Google Scholar] [CrossRef] [Green Version]
- Zhang, S.; Kai, C.; Liu, B.; Zhang, S.; Wei, W.; Xu, X.; Zhou, Z. Facile fabrication of cellulose membrane containing polyiodides and its antibacterial properties. Appl. Surf. Sci. 2020, 500, 144046. [Google Scholar] [CrossRef]
- Yang, Y.; Zheng, Z.; Lin, J.; Zhou, L.; Chen, G. Effect of KI Concentration in Correcting Tank on Optical Properties of PVA Polarizing Film. Polymers 2022, 14, 1413. [Google Scholar] [CrossRef]
- Yushina, I.D.; Kolesov, B.A.; Bartashevich, E.V. Raman spectroscopy study of new thia- and oxazinoquinolinium triodides. New J. Chem. 2015, 39, 6163–6170. [Google Scholar] [CrossRef]
- Bartashevich, E.V.; Grigoreva, E.A.; Yushina, I.D.; Bulatova, L.M.; Tsirelson, V.G. Modern level for the prediction of properties of iodine-containing organic compounds: Iodine forming halogen bonds. Russ. Chem. Bull. Int. Ed. 2017, 66, 1345–1356. [Google Scholar] [CrossRef]
- Kowczyk-Sadowy, M.; Świsłocka, R.; Lewandowska, H.; Piekut, J.; Lewandowski, W. Spectroscopic (FT-IR, FT-Raman, 1H- and 13C-NMR), Theoretical and Microbiological Study of trans o-Coumaric Acid and Alkali Metal o-Coumarates. Molecules 2015, 20, 3146–3169. [Google Scholar] [CrossRef] [PubMed] [Green Version]
- de Souza, M.L.; Otero, J.C.; López-Tocón, I. Comparative Performance of Citrate, Borohydride, Hydroxylamine and β-Cyclodextrin Silver Sols for Detecting Ibuprofen and Caffeine Pollutants by Means of Surface-Enhanced Raman Spectroscopy. Nanomaterials 2020, 10, 2339. [Google Scholar] [CrossRef] [PubMed]
- Vanholme, B.; El Houari, I.; Boerjan, W. Bioactivity: Phenylpropanoids’ best kept secret. Curr. Opin. Biotechnol. 2019, 56, 156–162. [Google Scholar] [CrossRef]
- Rahma, A.; Munir, M.M.; Khairurrijal, K.; Prasetyo, A.; Suendo, V.; Rachmawati, H. Intermolecular Interactions and the Release Pattern of Electrospun Curcumin-Polyvinyl (pyrrolidone) Fiber. Biol. Pharm. Bull. 2016, 39, 163–173. [Google Scholar] [CrossRef] [PubMed] [Green Version]
- D’Amelia, R.P.; Gentile, S.; Nirode, W.F.; Huang, L. Quantitative Analysis of Copolymers and Blends of Polyvinyl Acetate (PVAc) Using Fourier Transform Infrared Spectroscopy (FTIR) and Elemental Analysis (EA). World J. Chem. Edu. 2016, 4, 25–31. [Google Scholar] [CrossRef]
- Geetanjali, R.; Sreejit, V.; Sandip, P.; Preetha, R. Preparation of Aloe vera mucilage-ethyl vanillin Nano-emulsion and its characterization. Mater. Today Proc. 2021, 43, 3766–3773. [Google Scholar] [CrossRef]
- Carroll, K.C.; Morse, A.M.; Mietzner, T.; Miller, S. Jawetz, Melnick and Adelberg’s Medical Microbiology, 27th ed.; International Edition; Mc Graw-Hill Education: New York, NY, USA, 2016; ISBN 978-1-25-925534-2. [Google Scholar]
- Wiley, J.M.; Sherwood, L.M.; Woolverton, C.J. Prescott’s Microbiology, 10th ed.; Mc Graw-Hill Education: New York, NY, USA, 2016; ISBN 978-1259281594. [Google Scholar]

| Group | AV-PVP-TCA-I2 | [41] | [90] | [91] | [23] | [15] | [92] |
|---|---|---|---|---|---|---|---|
| I2 [I2…I−] | sh,m84* sh,m159*νas | sh,w80* | m85* m160*νas | ||||
| m166*νas m169*νas sh,m171*νs w176*νs | s169*νas | s169 νs I2 | |||||
| w179*νs | |||||||
| vw183*νs vw187*νs | w189*ν | ||||||
| I3− [I-I-I−] | sh,s62ν2bend s66 δdef sh,m82ν2bend m91ν1,s w100ν1,s vs112ν1,s w238+2ν1,s | sh,w61 δdef sh,w70 ν2bend | sh60 δdef sh,w75ν2bend | m85ν2bend | |||
| vs110ν1,s vw222+2ν1,s | s110ν1,s vw221 2ν1,s | 114ν1,s | vs111νs | vs116ν1,s vw235 2ν1,s | 108νs 110νs 218+νs | ||
| I3− [I-I…I−] | sh,w125ν3,as | m126ν3,as | |||||
| vw145ν3,as | m144ν3,as | m144ν3,as | 144ν3,as | m145νs | |||
| vw152ν3,as sh,m162ν3,as | sh,vw154ν3,as | 159νas | |||||
| w325+νas | vw334+νas | 322+νs 434+νs 542+νs |
| Group | 1 | 2 | 3 | 4 | 5 | [58] |
|---|---|---|---|---|---|---|
| I2 | 207 vs 210 vs | 205 | 206 vs | |||
| I3− | 290 s,sh 359 w,br 440 vw,sh | 290 358 | 288 m,br 356 w,br 440 vw,br | |||
| I− | 202 vs | 202 | 201 vs | |||
| AV/Aloin | 208 ** | 207 ** | 207 vs | |||
| PVP | 203–215 ** | 203–219 ** | 201 vs | 222 | 201 vs | |
| 210 vs | 210 vs | 202 vs | 203 vs | |||
| 216 sh | 218 s,sh | 209 vs | 210 vs,br | |||
| 211 br | 215 vs,br | |||||
| 213 sh 217 sh | 217 vs,br 221 s,sh | |||||
| PVP-I2 | 305 w,sh | 305 m,sh | 305 | 305 | 305 w,sh | |
| TCA | 203–215 ** 278 vs 283 s,sh 286 s,sh | 203–219 ** 278 vs 283 vs 286 vs | 209 218 276 |
| ν1,2 (O–H)s,a ν (COOH)a | ν (C–H)a | ν (CH2)s,a | ν (C-H)s ν (O-H) * | ν (C=O)a ν (C=C) | δ (C-H)a δ (CH2) δ (O-H) | ν (C-C) | ν (C-O) ν (N-H) | ν (C-O) | |
|---|---|---|---|---|---|---|---|---|---|
| A | 3308 | 2990 | 2953 | 2839 | 1646 (C=C) TCA 1651 (C=O) PVP 1656 (C=O) TCA | 1405 1417 δ (O-H) TCA 1450 1465 | 1314 1343 | 1290 TCA 1292 | 1014 1065 1074 1113 1205 1223 1275 |
| B | 3308 | 2989 | 2953 | 2839 | 1632 (C=C) TCA 1639 (C=O) PVP 1649 1655 (C=O) TCA | 1405 1417 δ (O-H) TCA 1425 1450 1465 1495 | 1314 1343 | 1289 TCA 1288 | 1016 1064 1073 1113 1205 1223 1275 |
| Group | AV-PVP-TCA-I2 | 1 | 2 | 3 | [95] | [96] | [13] |
|---|---|---|---|---|---|---|---|
| I2 | 22.8 m 23.8 m 25.5 m 27 m 30 m 37 vw | - | - | 28 m 40 w | 25 29 36 | - | 24.5 s 25 s 28 s 37 w 38 w 43 w |
| 46 w | 46 m | ||||||
| PVP | 11 m 20 m | 13 s | 10 s 19 s,br | 11 s,br 20 s,br | - | - | - |
| TCA | 11 m | - | - | - | - | 10 vs | - |
| 15 w | 19 w | ||||||
| 17 s | 20 w | ||||||
| 19 vs | 23 s | ||||||
| 24 m 26 m | 25 m 27 w | ||||||
| 29 m 32 w 34 w | |||||||
| AV | 16 m 22 m | 14 s | 14 s 21 s,br 22 s,br | - | - | - | - |
| Strain | Antibiotic | A | 1 + | 2 + | 3 + | S | B | M |
|---|---|---|---|---|---|---|---|---|
| S. pneumoniae ATCC 49619 | G | 18 | 14 | 12 | 0 | 3 | 24 | 20 |
| S. aureus ATCC 25923 | G | 28 | 17 | 13 | 11 | 7 | 40 | 35 |
| S. pyogenes ATCC 19615 | G | 25 | 16 | 12 | 9 | 4 | 24 | 19 |
| E. faecalis ATCC 29212 | G | 25 | 15 | 13 | 0 | 3 | 23 | 20 |
| B. subtilis WDCM 00003 | G | 21 | 14 | 0 | 0 | 4 | 23 | 16 |
| P. mirabilis ATCC 29906 | G | 30 | 0 | 0 | 0 | 0 | 0 | 0 |
| P. aeruginosa WDCM 00026 | G | 23 | 13 | 12 | 0 | 2 | 20 | 20 |
| E. coli WDCM 00013 | G | 23 | 13 | 0 | 0 | 0 | 26 | 16 |
| K. pneumoniae WDCM 00097 | G | 30 | 13 | 10 | 0 | 2 | 28 | 21 |
| C. albicans WDCM 00054 | NY | 16 | 46 | 25 | 13 * | 17 | 55 | 54 |
Publisher’s Note: MDPI stays neutral with regard to jurisdictional claims in published maps and institutional affiliations. |
© 2022 by the authors. Licensee MDPI, Basel, Switzerland. This article is an open access article distributed under the terms and conditions of the Creative Commons Attribution (CC BY) license (https://creativecommons.org/licenses/by/4.0/).
Share and Cite
Edis, Z.; Bloukh, S.H.; Sara, H.A.; Azelee, N.I.W. Antimicrobial Biomaterial on Sutures, Bandages and Face Masks with Potential for Infection Control. Polymers 2022, 14, 1932. https://doi.org/10.3390/polym14101932
Edis Z, Bloukh SH, Sara HA, Azelee NIW. Antimicrobial Biomaterial on Sutures, Bandages and Face Masks with Potential for Infection Control. Polymers. 2022; 14(10):1932. https://doi.org/10.3390/polym14101932
Chicago/Turabian StyleEdis, Zehra, Samir Haj Bloukh, Hamed Abu Sara, and Nur Izyan Wan Azelee. 2022. "Antimicrobial Biomaterial on Sutures, Bandages and Face Masks with Potential for Infection Control" Polymers 14, no. 10: 1932. https://doi.org/10.3390/polym14101932
APA StyleEdis, Z., Bloukh, S. H., Sara, H. A., & Azelee, N. I. W. (2022). Antimicrobial Biomaterial on Sutures, Bandages and Face Masks with Potential for Infection Control. Polymers, 14(10), 1932. https://doi.org/10.3390/polym14101932










